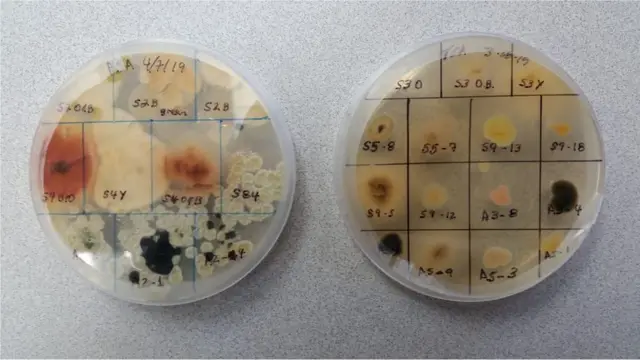
mikrobi

Zdravlje i životna sredina: Požari u prirodi mogu da rašire zarazne bolesti

Autor fotografije, D.VUONO
- Autor, Met Mekgrat
- Funkcija, Reporter za zaštitu životne sredine
Dim od požara iz divljine mogao bi da bude novi put širenja zaraza, pokazala su istraživanja.
Naučnici veruju da mikrobi i gljivice mogu da prežive u dimu.
Autori studije, objavljene u časopisu Nauka, veruju da organizmi iz zemljišta mogu da izazovu infekciju i da se na ovaj način rašire.
Oni tvrde da je potrebna veća kontrola i nadgledanje požara.
Decenijama se verovalo da ništa ne može da živi u dimu nastalom od požara.
Takođe, pretpostavlja se da dim predstavlja pretnju po ljudsko zdravlje, jer je pun čestica.
Ove mikroskopski vidljive čestice čađi jako nadražuju i izazivaju respiratorne i kardiovaskularne probleme.
Međutim, sada postoji bojazan da požar može da raširi mikrobe i gljivice.
Iz Američkog centra za kontrolu bolesti kažu da su vatrogasci u riziku da dobiju kokcidioidomikozu, infekciju koja se često dobija zbog gljivice koja počinje da se širi u vazduhu, kada se zemljište poremeti.

Autor fotografije, J.Juchtzer
Naučnici sada počinju da otkrivaju razmere potencijalne zaraze koju može doneti dim od požara.
Koristeći nove tehnike u prikupljanju mikroba u dimu, istraživači kažu da su otkrili oko 900 različitih tipova bakerija i oko 100 jedinstvenih gljivica.
„Vrste mikroba koje smo otkrili do sada u nekoliko studija su impresivne", kaže doktorka Leda Kobziar sa univerziteta Ajdaho.
„Ovi taksoni (grupa živih organizama) nisu otkriveni u vazduhu bez dima na istoj lokaciji pre požara, što je dokaz da sagorevanje u kombinaciji sa vetrovima aerosolizuju mikrobe u dim".
Istraživači veruju da mikrobi poskakuju na česticama u dimu.
Autor fotografije, LN Kobziar
Čak i u jakim požarima, naučnici su otkrili bakterije 300 metara iznad vatre. Više od 60 odsto njih je bilo živo.
Oni sumnjaju da određena materija kojom putuju štiti mikrobe od ultraljubičastog zračenja, koje bi moglo da ih ubije.
Iako su naučnici dokazali da u dimu postoji veliki broj bakterija koje mogu da prežive, ključno pitanje je koliku opasnost predstavljaju po zdravlje?
„Pronašli smo brojne mikrobe za koje je poznato da uzrokuju respiratorne bolesti - mikrobi koji mogu da izazovu astmu", rekla je doktorka Kobziar u pisanom odgovoru za BBC.
„Verovatnoća nastanka organizama koji se prenose sa zemljišta na biljke je velika, ali to još uvek nije testirano", dodaje.
Prethodne studije na uraganima i olujama pokazale su da ovi zarazni biološki agenti mogu preći velike daljine, mada to još uvek nije dokazano za bakterije koje se šire dimom.
Ipak, sposobnost dima da putuje oko sveta sugeriše da bi mogao biti „karika koja nedostaje" u objašnjavanju nekih obrazaca širenja zaraze.

Autor fotografije, LN Kobziar
„Kada se infekcija ustanovi kod pacijenta, potencijalni uzročnici koji se testiraju zasnivaju se na onome što živi u toj oblasti", kaže Kobziar.
„Međutim, dim prelazi granice između oblasti. Može se dogoditi da su se mnogi slučajevi infekcije pojavili usled prenošenja dima i mikroba izvan područja koje je za njih endemično".
Pratite Meta na Tviteru.

Možda će vas zanimati i naš video o gljivama i bakterijama koje mogu da proizvedu „zelenu energiju".

Pratite nas na Fejsbuku i Tviteru. Ako imate predlog teme za nas, javite se na [email protected]











